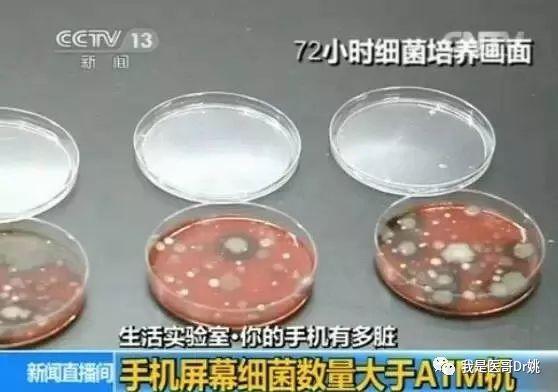
吃饭刷手机宜多吃,为什么刷手机的时候总想吃东西

作者:我是医哥Dr姚
最近,微博上有一条热门话题——
“#吃饭刷手机容易多吃#”!#清风计划# @头条健康
据说巴西拉夫拉死联邦大学和荷兰捂得热死大学医学中心的研究人员发现,一边吃饭一边刷手机容易让人摄入更多热量,不利于控制体重。

刷到这条微博的时候,医哥正在和朋友吃自助餐。
吓得我赶紧要了两个冰淇淋压压惊。
(原文如下)


其实,对于现代人来说,手机不离身已经是司空见惯的事情了。
吃饭刷手机,上洗手间刷手机,坐地铁刷手机,过马路也刷手机。
像医哥躺在床上都可以玩俩小时手机。

最近买了个防水的Mate20pro,已经发展到洗澡时刷手机的地步了。所以大晚上的千万不要突然和我视频,不然,额——
你会发现,我这款手机摄像功能那是相当地清晰……

撇开这条实验的设计是否合理,结论是否准确不谈。
单单说吃饭时看手机这条本身,就隐含了很多影响健康的因素在里面。
(说正事儿)

PART
01
首先,吃饭时刷手机,会导致注意力集中在手机上,这时候容易忽视手里的食物。吃多吃少看个人吃饭熟练程度和运用筷子配合的修为不论(在这条上中国人发明的筷子完胜西方人的刀叉!)但对于消化吸收食物那是相当的不利!
(所以微博评论里也有人说自己吃饭刷手机会瘦,我相信有这种情况,这些人要么本身消化吸收功能不好,要么一心两用的能力不行,反正医哥我本人肯定是长肉的那种……)

PART
02
其次,吃饭时刷手机容易闯祸。比如说,你吃饭时刷手机,可能没事;但你吃鱼时刷手机,就可能鱼刺卡喉。如果你吃火锅的时候还玩手机,就可能会把手机掉进火锅里……
(详见上一期《当iPhone X掉进火锅以后……》)

PART
03
最后,手机有多脏你们知道吗?BBC报道称,日常使用的手机屏幕细菌数,比厕所马桶圈上的细菌数还多出10倍!
你吃饭的时候,刷的不是手机,刷的是马桶圈!
中央电视台也报道过类似的实验。

“
当然,一周之前,医哥还吃过一次 iPhone X底料的火锅,至今平安无事。
(详见上一期《当iPhone X掉进火锅以后……》)
你们现在知道医哥有多 硬核 了吧?
”

PART
04
除了吃饭刷手机会有消化不良、病从口入等健康危害以外,如厕刷手机还容易导致便秘。
这一点咋听容易引起歧义:
为什么吃饭刷手机容易吃多,而上厕所刷手机却容易便秘呢?
这是不是就像”揉脸能使脸变小,揉胸能使胸变大“一样是个悖论呢?
其实细想也不是没有道理的,正常人吃饭比排便要熟练不是?毕竟常规量一个人一天吃三顿饭拉一次屎……虽然有时会腹泻,但是也会有夜宵和撸串的时候……
(好吧,这条的理由是我编的,我承认我编不下去了……)

PART
05
我们正经一点。长期刷手机还容易导致严重的“手机脖”(颈椎病)和“手机手”(假性类风湿)。

欧洲脊柱协会的声明指出,前倾看手机(60°),根据杠杆作用以及重力作用,颈部重量要承受25Kg以上的重量。(这是平均而言,对于医哥这种 头大星人 来说压力山大)

PART
06
此外,睡前看手机,平卧位看手机,不仅严重影响睡眠质量,还会导致视力下降的可能,严重者结膜出血、眼底出血,甚至视网膜剥脱!

当然,在这里也要顺便辟个谣,
那些说手机辐射会引起脑肿瘤的说法并没有足够的科学依据,除非你用的还是“大哥大”。

PART
07
除了健康问题以外,刷手机导致安全隐患也非常严重。
比如:上下楼梯刷手机。
上下地铁刷手机。
过马路刷手机。
甚至开车都刷手机!

在这里,北京市第三区交通委提醒您:

话说以前,医哥和朋友们吃个饭,一帮人坐在饭桌上,都在刷手机!连转个盘子夹个菜都不肯好好说话,非要在群里发消息!
中国移动
18:35
78%
微信(15)
龘贤居周末聚餐群(9)

我刚才在忙着刷微博呢,你叫我干啥来着?
我刚才想吃你面前那盘炒腰花来着,叫你转一下台面。你这货一边刷手机一边动筷子!我眼睁睁看着你把一盘炒腰花给吃完了……


你获得了一亿元
(你的钱包空间已不足,请把
钱花光以后再来领取。)





这算赔我的炒腰花?
END
泡面只需要三分钟
泡我只需要点赞并分享朋友圈